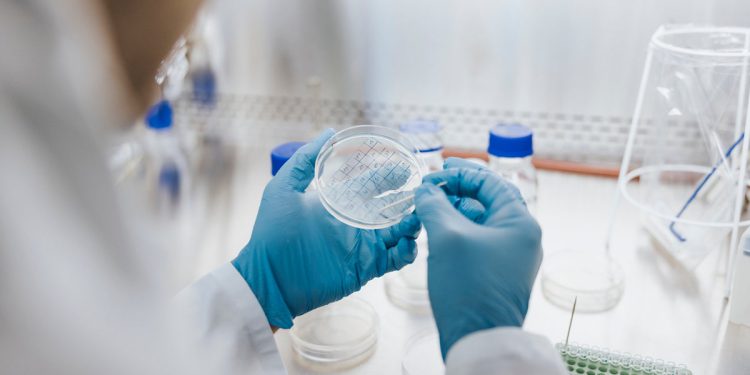
Upozorenje na gljivu ubojice koje bi moglo zaraziti milijune dok se širi po Europi

Ubojita gljiva trebala bi se širiti kroz nove dijelove Europe zbog rastućih temperatura, prema novim istraživanjima klimatskih promjena.
Aspergillus, vrsta plijesni koja može uzrokovati probleme s plućima i disanjem ako inficira čovjeka, može zaraziti milijune ljudi godišnje, jer se širi u sjevernije zemlje u Europi, Aziji i Americi zbog rastućih temperatura, pokazuje studija.
Norman Van Rhijn, znanstveni suradnik Wellcome Trust sa Sveučilišta Manchester, koji je automatizirao studiju, rekao je da se svijet približava prekretnici u vezi s porastom gljivičnih patogena, koji uspijevaju u velikom broju okruženja, uključujući unutarnje kuće.
Gljivične infekcije bit će faktor u milijunima smrti svake godine, rekao je g. Rhijn.
Aspergillosis, plućna bolest uzrokovana sporama Aspergillusa koja se može proširiti na druge ljudske organe, jedna je takva bolest.
Govoreći za FtGospodin Van Rhijn je rekao: “Govorimo o stotinama tisuća života i kontinentalnom pomaku u raspodjeli vrsta. U 50 godina, gdje stvari rastu i ono što ste zaraženi, bit će potpuno drugačije.”
Aspergillus može imati pozitivne koristi i koristi se u industrijskoj i proizvodnji hrane, uključujući fermentaciju sojinog umaka i sake.
Udisanje njegovih spora ne čini sve bolesne, ali smrtonosna gljiva može biti posebno prijeteće onima s uvjetima poput astme, cistične fibroze ili oslabljenog imunološkog sustava.
Ali gljivična istraživanja pokazuju da bi se Aspergillus fumigatus mogao proširiti na dodatnih 77 posto teritorija do 2100. godine kao rezultat svjetske teške uporabe fosilnih goriva, potencijalno izlažući devet milijuna ljudi u Europi infekciji, navodi Ft.
Vrste mogu brzo rasti u visokim temperaturama u kompostu, objašnjavajući zašto uspijeva u unutarnjoj temperaturi ljudskog tijela 37C.
“Njegov životni stil u prirodnom okruženju možda je pružio Aspergillus fumigatus s fitness prednosti potrebnom za koloniziranje ljudskih pluća”, rekla je profesorica Elaine Bignell, ko-direktorica u MRC centru za medicinsku mikologiju na Sveučilištu Exeter.
Druga vrsta, Aspergillus flavus, živi na usjevima i mogla bi se proširiti na dodatnih 16 posto teritorija u Sjevernoj Kini, Rusiji, Skandinaviji i Aljasci do 2100. godine, dodali su istraživači. Neka postojeća područja u afričkim zemljama i Brazil također mogu biti neugodno – što bi moglo biti štetno za lokalne ekosustave.
Darius Armstrong-James, profesor zaraznih bolesti i medicinske mikologije na Imperial College Londonu, rekao je za FT: “Postoje ozbiljne prijetnje ovog organizma i u smislu ljudskog zdravlja i sigurnosti hrane.”